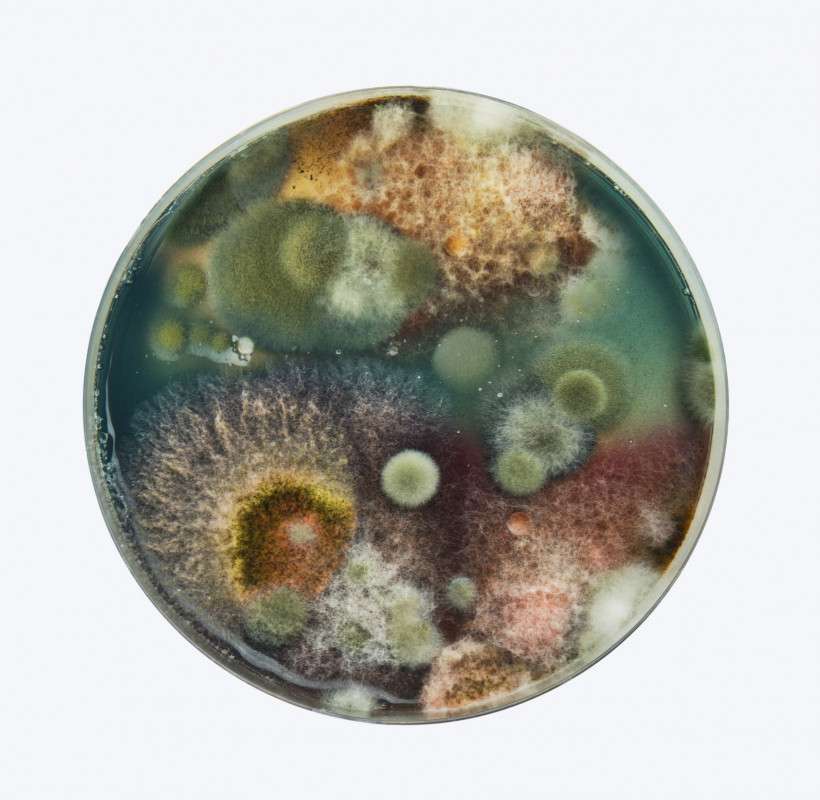

September 16, 2025
What Slime Mold Revealed About Tokyo’s Railway System
Slime mold biology meets urban design: how a brainless organism confirmed the genius of Tokyo’s railways and may inspire future infrastructure
When it comes to solving big problems, humans have often turned to nature for inspiration. Velcro was inspired by the tiny hooks on burdock burrs; the bullet trains owe their aerodynamic noses to the streamlined beak of a kingfisher. But here’s a story that might surprise you: Tokyo’s famously efficient railway network found a kindred spirit in a blob of slime.
Led by Atsushi Tero from Hokkaido University, researchers discovered that Physarum polycephalum, a humble slime mold, could replicate—and in some cases improve upon—Tokyo’s rail system.
Using oat flakes and its natural tendency to optimize, the slime mold built networks that rivaled human-made designs in efficiency and resilience. It’s a case study of how one of the simplest organisms on Earth can offer profound insights into some of humanity’s most complex systems, even making them more cost-effective.
The Slime Mold Experiment
The setup was as clever as it was simple. Researchers placed oat flakes on a petri dish to represent Tokyo’s major areas and its surrounding cities, then introduced the slime mold.
At first, it spread out in all directions, covering as much ground as possible. But as it encountered the oat flake “hubs,” it formed connections, gradually thinning out redundant paths and reinforcing efficient ones.
The final result? A network of protoplasmic tubes that looked eerily similar to Tokyo’s railway map. Even more impressive, the slime mold didn’t just mimic the network––it added strategic cross-links and redundancies that made the system more resilient to disruptions, all while minimizing “cost,” measured as the total length of its paths.

Lessons from a Brainless Architect
How does a slime mold, without a brain or a blueprint, achieve such sophisticated results?
The secret lies in its decentralized decision-making. Instead of relying on a central control system, Physarum reacts to local conditions, reinforcing pathways that work and discarding those that don’t. This trial-and-error process allows it to adapt quickly and efficiently to environmental changes.
Tokyo’s railway planners face similar challenges, albeit on a much larger scale. Connecting densely populated urban centers while navigating natural obstacles like rivers and mountains requires a delicate balance of strategy.
The slime mold’s networks suggest that small adjustments to increase resilience could make a big difference—particularly in a city prone to earthquakes and typhoons. Tokyo’s train network might be globally impressive. But still, if you’re ever lost in Shinjuku Station, the largest in the world, just remember: even a slime mold would have had a hard time figuring that place out on
the first try.
Read more about Japan’s ingenious rail system,
Tokyo Train Guide: Toei Oedo Line
Are Trains in Tokyo Safe for Women? A List of Women-Only Cars in Tokyo